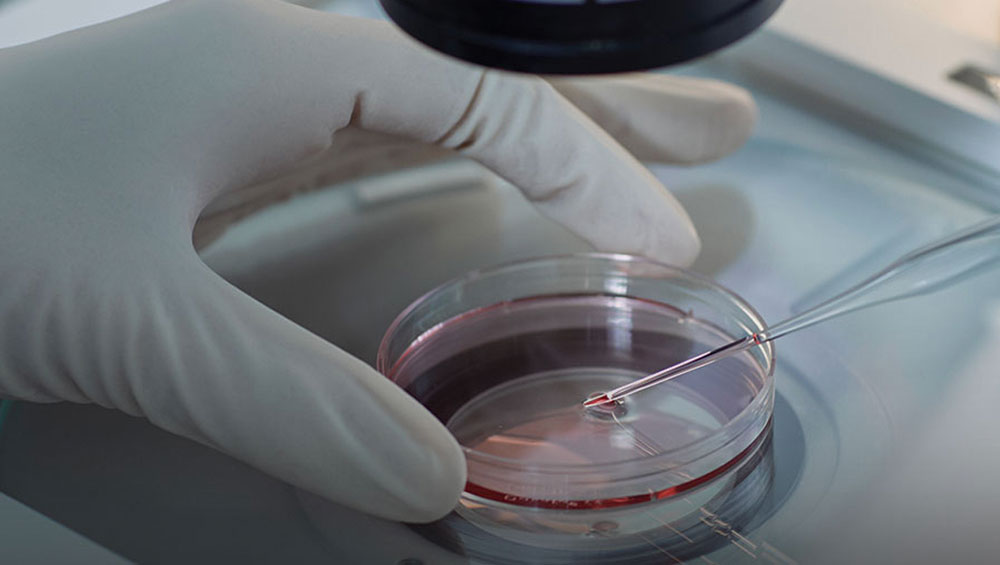

บริการทำเด็กหลอดแก้ว
SHOW ALLSERVICES
Next Generation Sequencing (NGS)
คือเทคโนโลยีการหาลำดับเบสของโครโมโซมที่มีความละเอียดสูง โดยสามารถตรวจคัดกรองความผิดปกติของโครโมโซมได้ทั้งหมด 23 คู่ และยังสามารถตรวจหาการเพิ่มขึ้นหรือลดลงของจำนวนโครโมโซมได้อย่างถูกต้อง แม่นยำ รวมทั้งการกลายพันธุ์ของโครโมโซมบางชนิด ที่ BIC กระบวนการทดสอบทุกขั้นตอนจะมีรูปแบบการทำงานร่วมกันระหว่างผู้เชี่ยวชาญ 2 ท่าน เพื่อเป็นการตรวจทานผลการทดสอบ 2 ทางเสมอ โดยมีจุดประสงค์เพื่อต้องการให้ผลการทดลองออกมามีความถูกต้องแม่นยำมากที่สุด